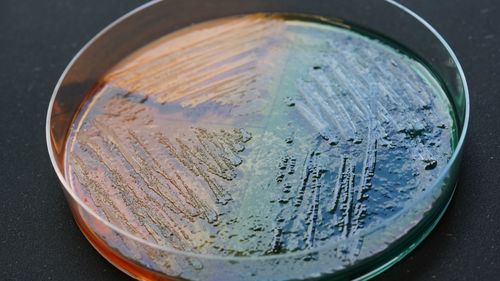

Prof. Dr. Maximilian Bockhorn
Universitätsklinik für
Allgemein- und Viszeralchirurgie am Klinikum Oldenburg
Newsletter abonnieren
Seit 2012 bildet die Universität Oldenburg an der Fakultät VI – Medizin und Gesundheitswissenschaften gemeinsam mit dem Klinikum Oldenburg, dem Pius-Hospital Oldenburg, dem Evangelischen Krankenhaus Oldenburg und der Karl-Jaspers-Klinik angehende Ärztinnen und Ärzte aus. Gemeinsam bilden die Partner die Universitätsmedizin Oldenburg. Über Aktuelles aus Forschung, Studium und Lehre informiert vier Mal im Jahr dieser Newsletter.
zur Anmeldung
(Versand ca. 3x jährlich)
Kontakt
Redaktion: Sonja Niemann
Newsletter der Universitätsmedizin Oldenburg
Ausgabe 3 | Juli 2023

Liebe Leserinnen und Leser,
endlich konnten wir kürzlich wieder eine Absolventinnen- und Absolventenfeier veranstalten. 257 Menschen haben in diesem und in den vorangegangen Pandemiejahren einen Abschluss in den Studiengängen unserer Fakultät erworben, promoviert oder sich habilitiert.
Die Zahl der Absolventinnen und Absolventen soll nach dem Willen der Politik steigen – und sie muss es angesichts des bevorstehenden Mangels an ärztlichen Fachkräften auch. Umso irritierter haben wir zur Kenntnis genommen, dass die Landesregierung in ihrem Haushaltsentwurf keine Mittel für die UMO vorgesehen hat. Das konterkariert die im Koalitionsvertrag formulierten Absichten der Regierungsparteien. In den vergangenen elf Jahren sind wir, die Universität und die vier Kooperationskrankenhäuser, immer wieder in Vorleistung getreten. Es ist an der Zeit, dass das Land endlich zu seinem Wort steht.
Herzliche Grüße
Hans Gerd Nothwang, Dekan der Fakultät VI Medizin und Gesundheitswissenschaften
Forschung
Studium & Lehre
Neuberufene
Kurz notiert
- Hermine Heusler-Edenhuizen-Preis für zwei Forscherinnen
- Department Versorgungsforschung stellt Bericht vor
- Wichtiges Branchentreffen von Hörforschenden und Hörgeräteentwicklern in Oldenburg
- Jetzt für den Lauf der Allgemeinmedizin am 15. Oktober anmelden
- Menschen ab 50 Jahren für Hörstudie gesucht
- Lehrpraxen-Netzwerk wächst weiter
- Neurologischen Krankheiten auf der Spur: Probandinnen und Probanden gesucht
Veranstaltungen
Roboter-Operationen in der Chirurgie
4. Oldenburger Tag der Allgemeinmedizin
Unabhängige Fortbildungsveranstaltung mit praxisorientierten, interaktiven Workshops für Hausärztinnen und Hausärzte sowie Medizinische Fachangestellte
Genetik in der Medizin – wie viel Krankheit ist erblich?
Prof. Dr. Marc-Philip Hitz
Universitätsinstitut für Medizinische Genetik am Klinikum Oldenburg
Moderne Behandlungskonzepte bei eloquenten Hirntumoren
Prof. Dr. Johannes Woitzik
Universitätsklink für Neurochirurgie am Evangelischen Krankenhaus Oldenburg